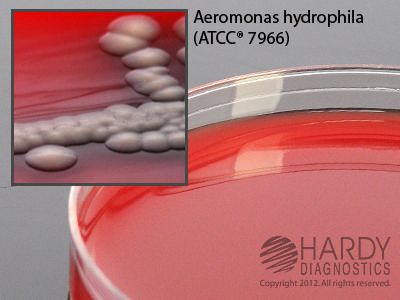

Blood Agar W/Ampicillin 15x100mm Plate , Pack Of 10
$ 36.59
|
|
Details:
Blood Agar, 5% Sheep In Tryptic Soy Agar (Tsa) Base^ Blood Agar, 5% Sheep In Tryptic Soy Agar (Tsa) Base, With Ampicillin, For Aeromonas, 15X100Mm Plate, For The Selective Isolation Of Aeromonas S
Additional Information
| SKU | 24027475 |
|---|---|
| UOM | Pack of 10 |
| UNSPSC | 41106212 |
| Manufacturer Part Number | A12 |
| Product Dimensions | 4X4X8 Inches. |
| Product Weight | 0.8 |
